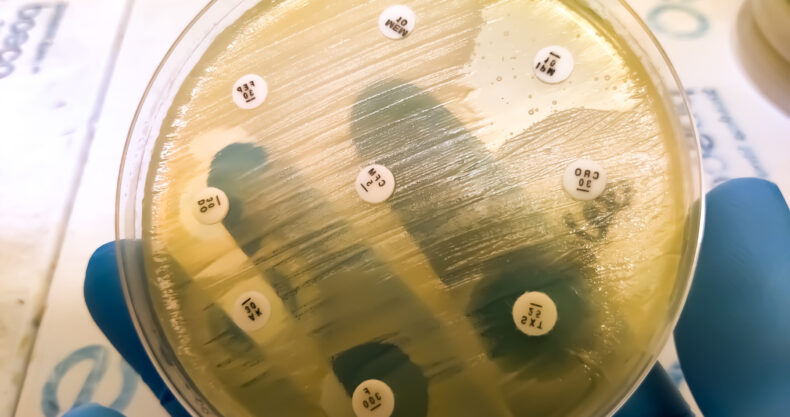

- 英文タイトル:Cefiderocol susceptibility of Stenotrophomonas maltophilia species complex and carbapenem-resistant Pseudomonas aeruginosa isolates from blood cultures at a university hospital in Tokyo, Japan
- 雑誌名:Journal of Global Antimicrobial Resistance
- 著者:Wataru Aoki, et al.
- 掲載年月:2025年7月7日
- URL:https://www.sciencedirect.com/science/article/pii/S2213716525001584?via%3Dihub
- DOI:https://doi.org/10.1016/j.jgar.2025.07.004
背景・目的
セフィデロコル(FDC)は、2019年に米国で、2020年に欧州で承認された抗菌薬である。米国感染症学会の2024年抗菌薬耐性グラム陰性菌感染症治療ガイダンスでは、メタロβラクタマーゼ産生カルバペネム耐性腸内細菌科細菌、治療困難な耐性緑膿菌(P. aeruginosa特に尿路感染症)Stenotrophomonas maltophilia complex(Stenotrophomonas maltophilia)などのカルバペネム耐性菌株に対して有望な効果を示している。日本でも最近承認されたものの、感受性データは依然として限定的である。本研究では、血流感染症におけるカルバペネム耐性P. aeruginosaおよびStenotrophomonas maltophilia (S. maltophilia) complexに対するFDC使用に焦点を当て、日本国内の血液培養から分離された菌株におけるFDC感受性を評価していく。
この記事の続きをお読みいただくには、
ログインまたは会員登録が必要です。